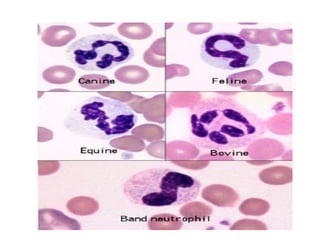

Le document traite de l'hématologie, en décrivant la composition du sang, les types de cellules sanguines et leur origine, ainsi que les rôles physiologiques du sang dans le transport des gaz, des nutriments et des déchets. Il aborde également la morphologie des érythrocytes, leur structure et fonction, ainsi que les conditions pathologiques affectant leur nombre et leur qualité. Enfin, des détails sur l'hémoglobine, son transport d'oxygène et de dioxyde de carbone, ainsi que l'érythropoïèse, sont fournis.